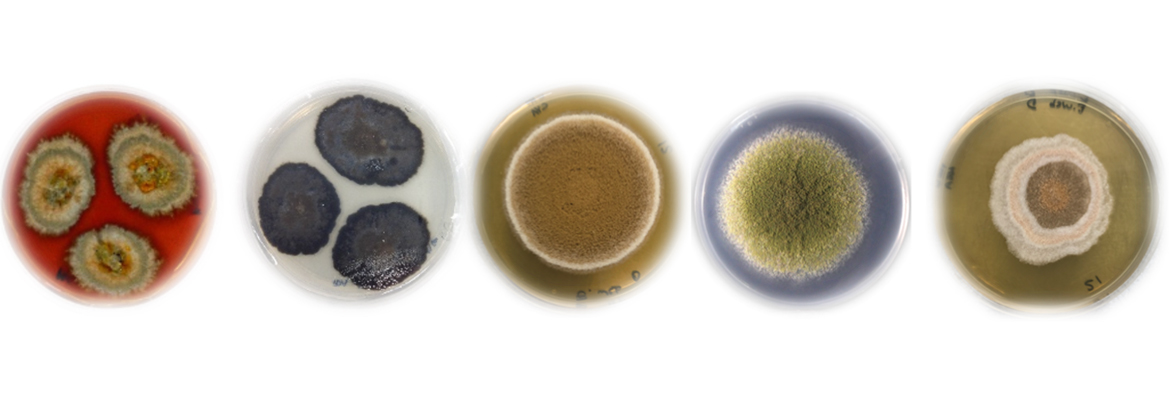
Various fungi in petri dishes

Rydym yn grŵp ymchwil sy'n gweithio ar ryngwyneb Cemeg a Bioleg gan ymchwilio i gynhyrchion naturiol o ffyngau. Mae ein labordy (i) yn defnyddio metabolomeg, geneteg a biowybodeg i ddarganfod cynhyrchion naturiol o ffyngau, (ii) yn datblygu offer genetig i bennu llwybrau biosynthetig ac (iii) yn ymchwilio i rolau ecolegol a bioweithgareddau cynhyrchion naturiol. Am ragor o wybodaeth, ewch i'n gwefan.
Staff Cyswllt
Shumukh Alharthi (Myfyriwr PhD)
Claudio Greco (PI)
Babalwa Tembeni (Ôl-ddoethuriaeth)
Shumukh Alharthi (Myfyriwr PhD)
Maya Macay (myfyriwr ymchwil)


Prosiect cysylltiedig
- Darganfyddiad gwrth-heintus o ecosystemau cystadleuol (Cymrodoriaeth Ddarganfod y BBSRC, 2021-2024)
- Sgrinio, darganfod a chymhwyso cynhyrchion naturiol bioactif newydd (ysgoloriaeth PhD, Llywodraeth Saudi Arabia)
- Datgelu cemoamrywiaeth ffwngaidd (ysgoloriaeth PhD, Prifysgol Abertawe/EPSRC)
Cyrsiau Perthnasol
Bydd swyddi a ariennir yn cael eu hysbysebu yma pan fyddant ar gael ac ar wefan y Brifysgol. Rydym bob amser yn agored i ymholiadau anffurfiol gan fyfyrwyr ac ymchwilwyr ôl-ddoethurol llawn cymhelliant sydd â diddordeb mewn:
- Biosynthesis cynnyrch naturiol a chymwysiadau
- Biotechnoleg ffwngaidd
- Geneteg ffwngaidd
- Metabolomeg a Biowybodeg
Os oes gennych ddiddordeb mewn prosiect MSc, MRes neu PhD gyda ni, edrychwch hefyd ar hafan Prifysgol Abertawe i gael rhagor o wybodaeth am ein rhaglenni ôl-raddedig.
Cyfleusterau
Mae gan ein labordy fynediad at offer microbioleg a chemeg organig cyffredinol, gan gynnwys:
- Cypyrddau gwyntyllu
- UHPLC-HRMS (Agilent Q-TOF)
- HPLC-PDA/MS dadansoddol paratoadol (Dyfroedd)
- Genevac
- Gorchuddion bioddiogelwch CAT II
- Thermocylchyddion – PCR a qPCR
- Nanodrop a Qubit
- Darllenwyr platiau
- Deoryddion ysgwyd a statig
- Awtoclafau
- Rhewsychwr
- Rotor+
- Flowbot
